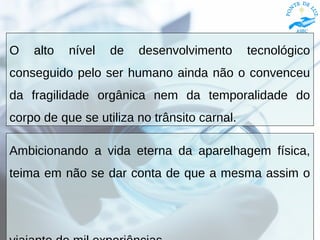
O alto nível de desenvolvimento tecnológico
conseguido pelo ser humano ainda não o convenceu
da fragilidade orgânica nem da temporalidade do
corpo de que se utiliza no trânsito carnal.
Ambicionando a vida eterna da aparelhagem física,
teima em não se dar conta de que a mesma assim o

O documento discute os tópicos de engenharia genética, clonagem, criogenia à luz do espiritismo. A manipulação genética e a busca pela eternidade da vida física são vistas como tentativas de contornar as leis divinas da evolução espiritual através das provações terrenas. A ciência deve ser guiada por uma ética que respeite os limites impostos pela natureza e destino do espírito.



![Engenharia GenéticaA Divindade tem facultado que as aflições
mais rudes, em razão do progresso, […]
venham a ser diminuídas pouco a pouco,
abrindo espaços no seu processo orgânico e
psíquico para mais saúde, mais bem-estar
e mais alegria de viver.
A busca pelo desenvolvimento do
conhecimento genético tem um lado muito
respeitável, sem dúvida, mas que foge ao
programa da reencarnação de muitos
Espíritos endividados que, se liberados da
injunção aflitiva, incidirão em outros
mecanismos depuradores.](https://image.slidesharecdn.com/engenhariagenetica-190210165907/85/Engenharia-Genetica-4-320.jpg)
![O corpo […] é resultado da conduta
anterior do Espírito, que programa
as suas necessidades na forma, a
fim de crescer e evoluir,
transformando conflitos em paz,
débitos em créditos, mazelas em
esperanças.
A vida é trabalhada por um princípio
de ética divina, que não pode ser
manipulada ao prazer da
insensatez, sem que disso não
decorram consequências
imprevisíveis para os seus
infratores.](https://image.slidesharecdn.com/engenhariagenetica-190210165907/85/Engenharia-Genetica-5-320.jpg)